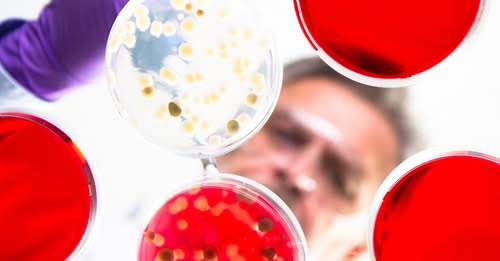

A HungaroMet közzétette a következő hét időjárás-előrejelzését, amiből…


Ilyen ajánlatról sem hallani mindennap! 



Visszajött kétszettes hátrányból Scott Williams, de Wattimena így is nyerni tudott! 💪 


A Fővárosi Állat- és Növénykert különleges karácsonyi etetésén minden állat kapott finomságot: a vöröspandák, a medvék és az elefántok is ettek, sőt, még a búvár is beúszott az akváriumba, hogy…

Magyarország ellenállásának köszönhetően hazánk kimarad a „háborús kölcsön” programból, ahogyan Csehország és Szlovákia is.

A Nézőpont Intézet vezetője szerint a Tisza Párt elnökének viselkedése méltatlan még egy önjelölt kormányfőhöz is.



Nincs specifikus antivirális gyógyszer vagy jóváhagyott…